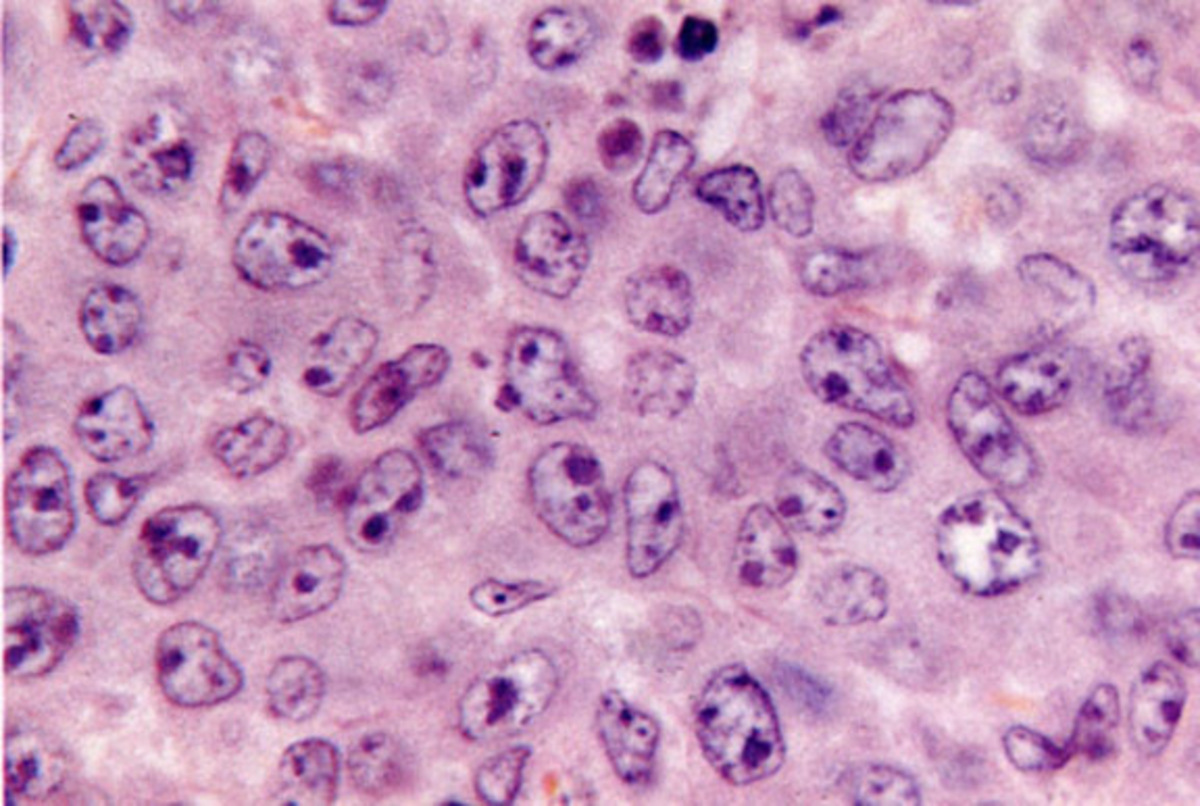
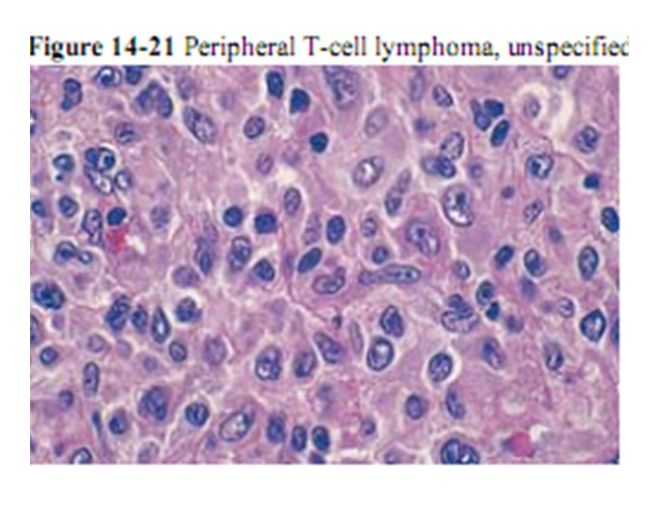

T cell lymphoma
Духи кевин
Поток не воспроизводится
Выплата наличными нерезиденту
Математика 5 класс стр 31 упр 137
Карта продвижения российских войск 2025
Слушать китов в океане
Песня на английском сестер
05 12 84
Czech massage 387
Живи в курортном спб
Какие решения принял 3 съезд советов
Фрукты конспект логопедического занятия в подготовительной группе
Кот боки
T cell lymphoma 97 фото